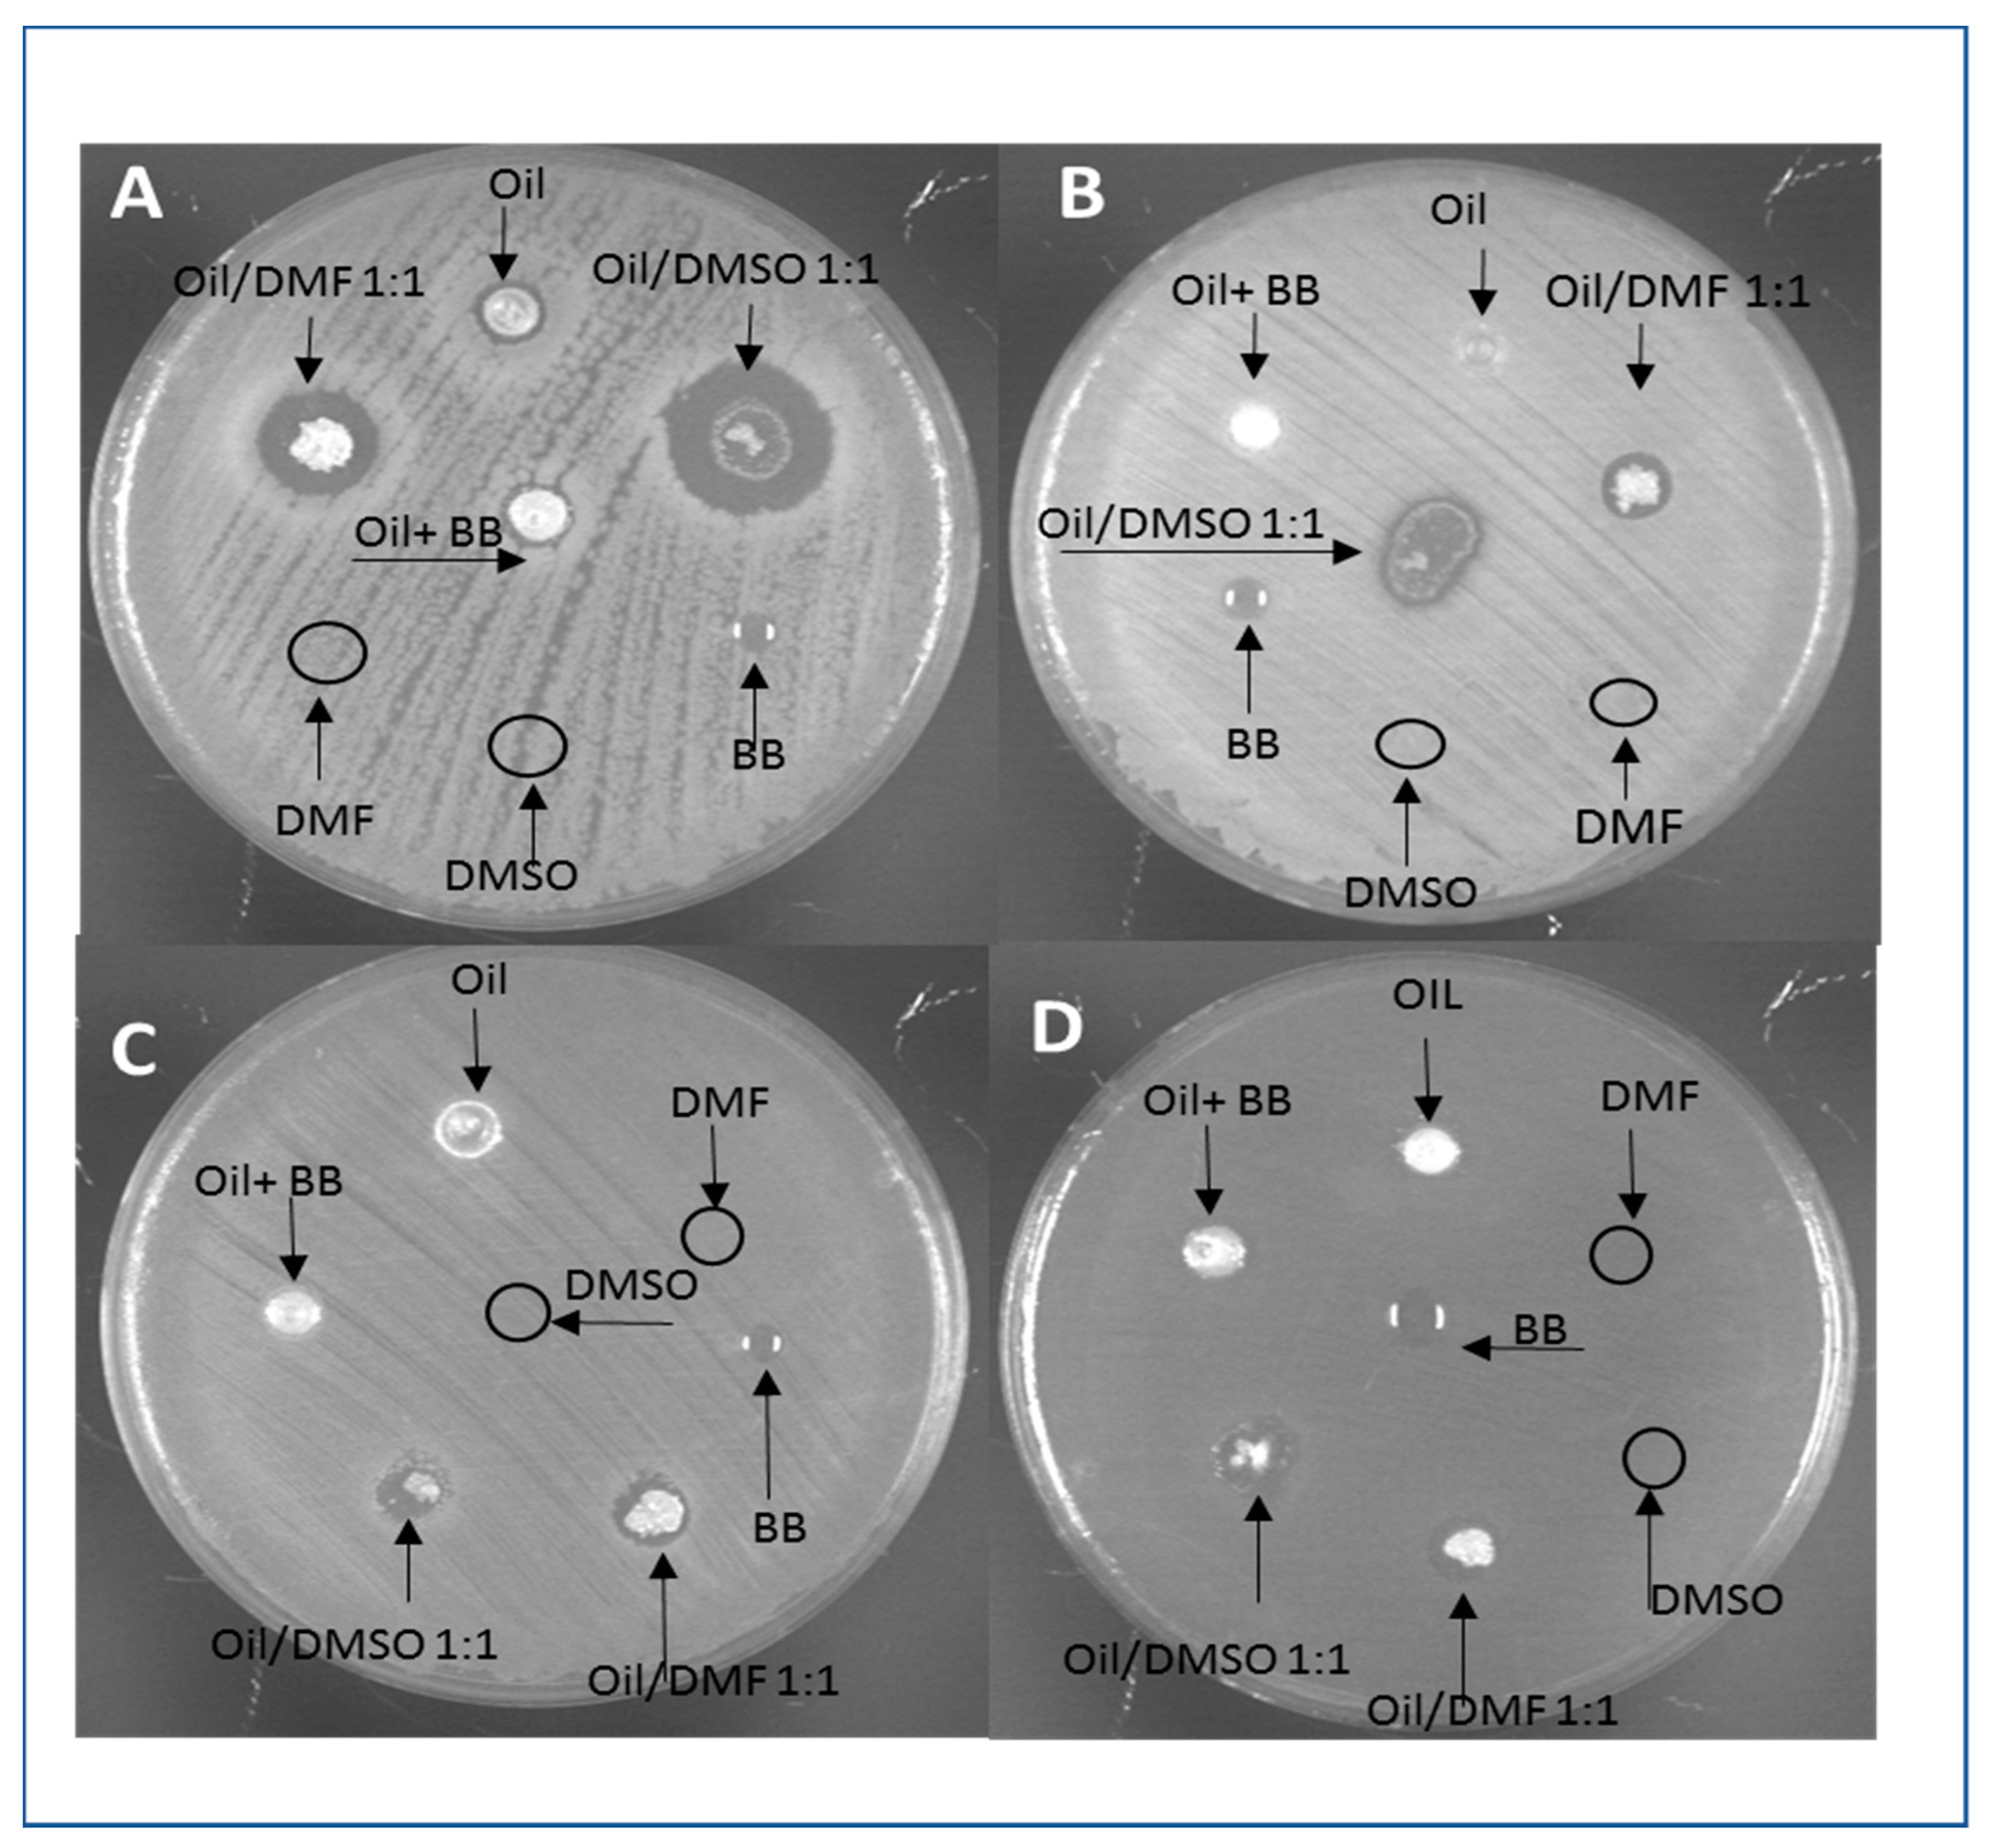
Animals 11 00783 g001 Animals 11 00783 g001
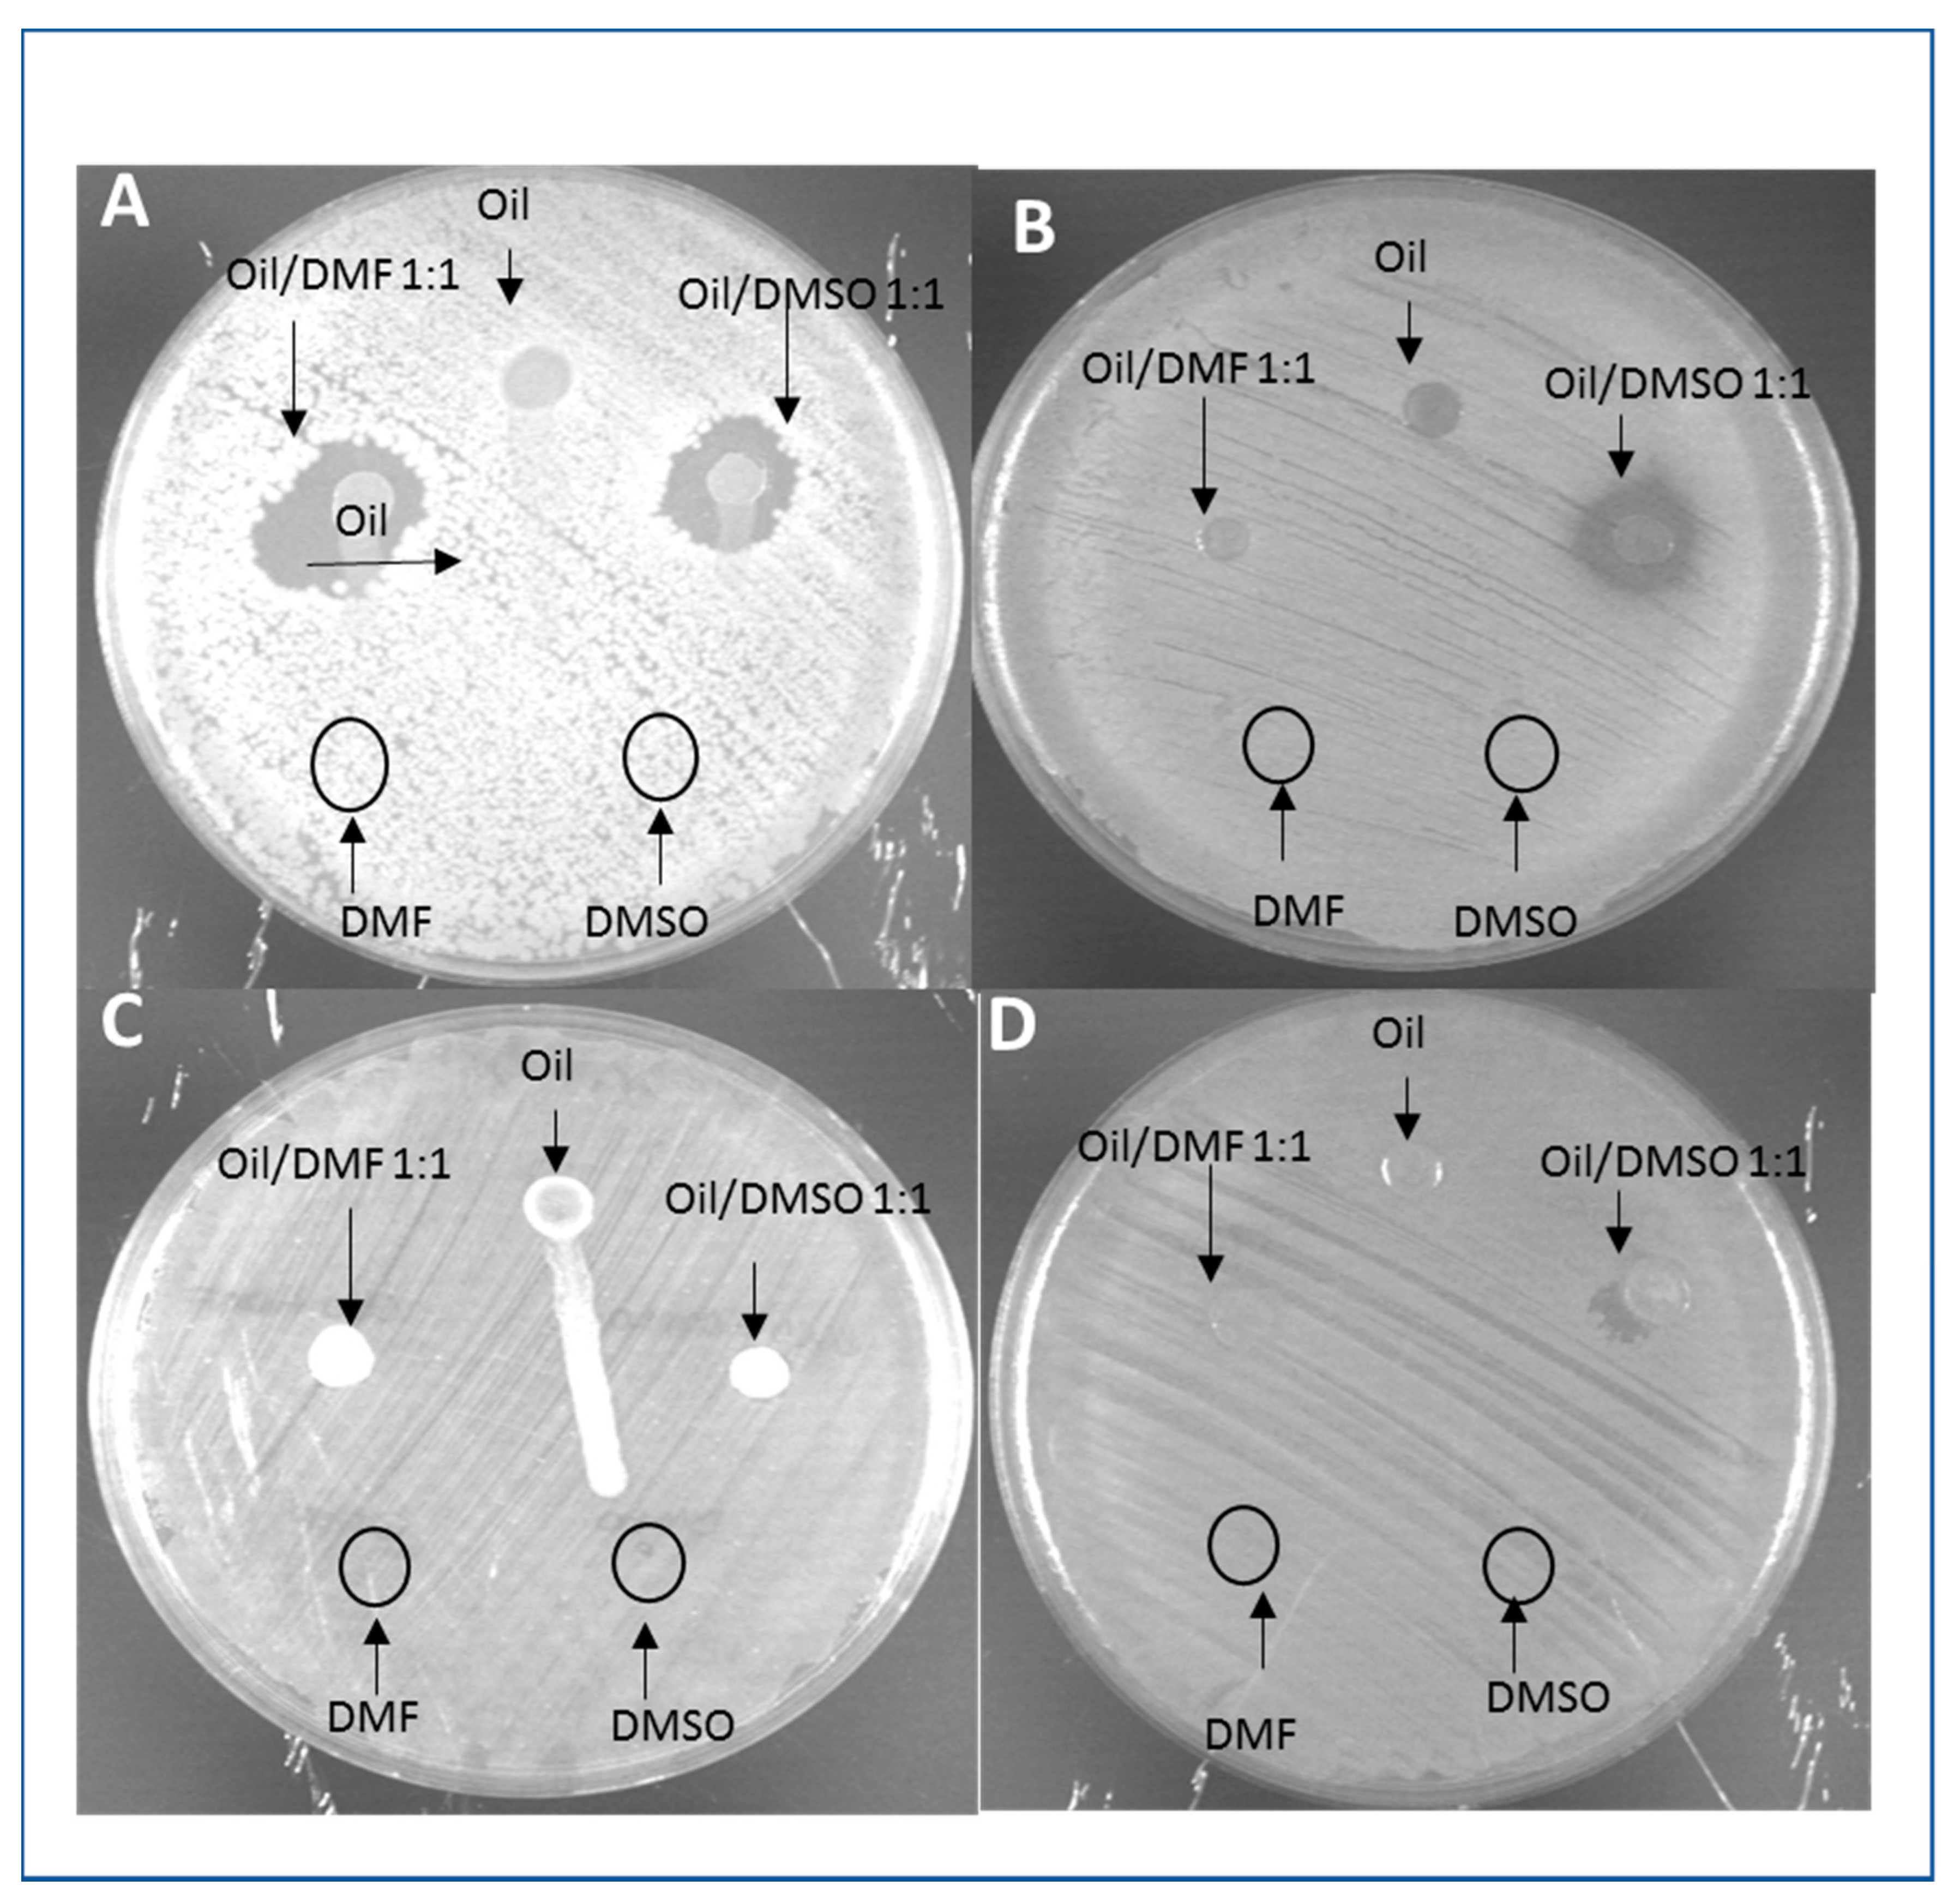
Animals 11 00783 g002 Animals 11 00783 g002

Mechanical Processing of Hermetia illucens Larvae and Bombyx mori Pupae Produces Oils with Antimicrobial Activity
Abstract
Simple Summary
Abstract
1. Introduction
2. Materials and Methods
2.1. Insect Rearing
2.2. Insect Drying
2.3. B. mori Cocoons Treatments
2.4. Extraction Tests
- (1)
- Solvent extraction: this extraction was carried out to quantify the exact amount of oil contained in the BSFL; however, chemical extraction was not considered as a possible option from the perspective of a circular economy. The larvae were pressed and three meal replicates of 10 g each were extracted with solvents in 100 mL of ether, at room temperature, for 30 min, under continuous agitation using a magnetic stirrer. Then, the mixture BSFL meal/solvent was transferred into a separating funnel with 2 mL of a 20% NaCl solution; after the elimination of the aqueous phase, the lipophilic phase was centrifuged for 20 min at 15,000 rpm at 4 °C. The meal residue was re-extracted with 100 mL of ether for 15 min. The two ether extracts were pooled together, evaporated to dryness at 30 °C using a rotating evaporator, and then weighed to determine the amount of extracted lipids.
- (2)
- Aqueous extraction:
- (a)
- Meal aqueous extraction: BSFL were ground, then 100 g of the meal were added to 500 mL of cold water in a beaker on a heating plate under agitation by magnetic stirrer. Thermoregulation was set at 50 ± 2 °C during the extraction phase (3 h). Then, the mixture meal/water was poured into an Imhoff cone, which was maintained at a 2 °C for 48 h. Finally, the separation state of the lipid phase at the surface and the meal sedimentation were checked.
- (b)
- Whole larva aqueous extraction: 50 g of dried larvae and 500 mL of water pre-heated at (i) 70 °C or (ii) 100 °C were put into flasks with taps on heating plates and agitated with magnetic stirrers. Thermoregulation was set at (i) 70 ± 2 or (ii) 100 ± 2 °C during the extraction phase (1 h). Then, the larvae were drained and the extraction water from the two samples at different temperatures was poured into two separate Imhoff cones, which were maintained at 2 °C overnight, to evaluate the quantity of extracted lipids that emerged to the water surface.
- (3)
- Naviglio extraction: the extracts were obtained by using a rapid solid–liquid dynamic extraction (RSLDE) through a Naviglio Extractor (NE) (AtlasFiltri Engineering, Padua, Italy). This equipment allows a rapid solid–liquid extraction, maintaining the liquid in contact with the solid in programmable pressurization–depressurization cycles. The functioning of Naviglio Extractor [12,13] is based on a suction effect, generated by the compression of an extracting solvent on solids at a pressure of about 6-8 bar for a determinate time, and followed by an immediate decompression at a pressure of about 1 bar, i.e., atmospheric pressure. The rapid release of the extracted liquid from the solid matrix, as a consequence of the pressure gradient, mechanically transports the extractable compounds contained in the solid matrix into a solution.
- (a)
- Test 1 (maceration at 80 °C and NE extraction for 1 h): 50 g of dried larvae were placed in 600 mL of distilled water at 80 °C for 5 min. After the blanching process, the material was transferred to the 500 cc NE chamber for 1 h (static phase: 1 min; dynamic phase: 2 min).
- (b)
- Test 2 (NE extraction with water/ethanol 50:50 (v/v) for 24 h): 50 g of dried larvae were extracted with 600 mL of the hydroalcoholic solution using the 500 cc NE chamber for 24 h (static phase: 1 min; dynamic phase: 2 min).
- (c)
- Test 3 (NE Extraction with 96% ethanol (v/v) for 24 h): 50 g of dried larvae were extracted with 600 mL of 96% (v/v) ethyl alcohol by means of the 500 cc NE chamber for 24 h (static phase: 1 min; dynamic phase: 2 min).
2.5. Crushing of BSFL
2.6. Crushing of SP
2.7. Chemical Analyses
- Free fatty acids were determined by means of volumetric titration using phenolphthalein as an indicator using standard method [16].
- Peroxide value was determined by means of volumetric titration based on the liberation of iodine from potassium iodide in presence of hydroperoxides. A starch aqueous solution was used as an indicator according to [17].
- Fatty acid composition was determined according to [18]. The analyses were carried out by a gas-chromatograph FOCUS (Thermoquest Instrument, Rodano, Italy) equipped with a flame ionization detector (GC-FID), using a capillary column (CP-Sil 88−l = 100 m, 0.32 mm i.d., film thickness 0.25 μm; Supelco, Bellefonte, PA, USA) after derivatization of fatty acids into the corresponding methyl esters, under the following experimental conditions: carrier gas He at a flow rate of 1.5 mL/min; split injection system with a splitting ratio 1:40; injector and detector temperatures set at 250 and 260 °C respectively; using the following program: 90–240 °C at 7 °C/min; injected quantity 1 μL.
2.8. Antimicrobial Assays
- Bacterial strains and growth conditions: Pseudomonas aeruginosa PAO1, Escherichia coli C1a, as Gram-negative, and Staphylococcus aureus ATCC 6538P and Bacillus subtilis ATCC 6633, as Gram-positive, were selected as model microorganisms to test the antimicrobial activity of H. illucens and B. mori oil. The strains were grown overnight in Luria-Bertani (LB) medium at 37 °C under 200 rpm shaking.
- Agar diffusion test: the antimicrobial activity of H. illucens and B. mori oil was tested by agar diffusion assay. Briefly, overnight LB bacterial cultures were inoculated on LB agar plates and let dry. A volume of 10 μL of oil or oil dissolved in solvents was loaded onto the inoculated plates. The oil samples were diluted 5-fold or 2-fold in dimethylsulfoxide (DMSO), N,N-dimethylformamide (DMF) and benzyl benzoate (BB). The activity of the solvents was checked as control. The plates were incubated at 37 °C for 24 h and the antibacterial effect was evaluated by measuring the growth inhibition halo. All experiments were performed in triplicate.
2.9. Statistical Analysis
3. Results
3.1. BSFL Aqueous Extraction
3.1.1. Meal Aqueous Extraction
3.1.2. Whole Larvae Aqueous Extraction
3.2. Tests with Naviglio Extractor
3.3. BSFL Pressing Process Efficiency
3.4. SP Pressing Process Efficiency
3.5. Chemical Analyses of BSFL Non-Defatted Meal and Oil
3.6. Chemical Analyses of B. mori Meal and Oil
3.7. Antimicrobial Assays
4. Discussion
4.1. Generalities
4.2. Comparison of BSFL and SP Derived Oil Obtained in this Study with Literature Data
4.3. Extraction Method Efficiency in Relation to Fat Distribution in the Insect Body
4.4. Impact of SP Preservation on Oil Quality and Extraction Efficiency
4.5. Antimicrobial Activity of BSFL and SP Oils: Possible Role of Fatty Acids
4.6. Antimicrobial Activity of BSFL and SP Oils: Possible Role of AMP
5. Conclusions
Supplementary Materials
Author Contributions
Funding
Institutional Review Board Statement
Data Availability Statement
Acknowledgments
Conflicts of Interest
References
- Cammack, J.A.; Tomberlin, J.K. The Impact of Diet Protein and Carbohydrate on Select Life-History Traits of The Black Soldier Fly Hermetia illucens (L.) (Diptera: Stratiomyidae). Insects 2017, 8, 56. [Google Scholar] [CrossRef]
- Choi, W.H.; Yun, J.H.; Chu, J.P.; Chu, K.B. Antibacterial Effect of Extracts of Hermetia illucens (Diptera: Stratiomyidae) Larvae against Gram-Negative Bacteria. Entomol. Res. 2012, 42, 219–226. [Google Scholar] [CrossRef]
- Muller, A.; Wolf, D.; Gutzeit, H.O. The Black Soldier Fly, Hermetia illucens—A Promising Source for Sustainable Production of Proteins, Lipids and Bioactive Substances. Z. Naturforsch. C 2017, 72, 351–363. [Google Scholar] [CrossRef] [PubMed]
- Param, D.; Venkatesh, K.R.; Ram, G.; Sangeeta. Analysis of Chemical Composition of Mulberry Silkworm Pupal Oil with Fourier Transform Infrared Spectroscopy (FTIR), Gas Chromatography/Mass Spectrometry (GC/MS) and its Antimicrobial Property. Asian J. Agric. Res. 2017, 11, 108–115. [Google Scholar] [CrossRef]
- Cecchini, M.; Langer, J.; Slawomirski, L. Antimicrobial Resistance in G7 Countries and beyond © OECD 2015. Available online: https://www.oecd.org/els/health-systems/Antimicrobial-Resistance-in-G7-Countries-and-Beyond.pdf (accessed on 8 March 2021).
- Antimicrobial Resistance: Background. Available online: http://www.fao.org/antimicrobial-resistance/background/en (accessed on 8 March 2021).
- Ribeiro da Cunha, B.; Fonseca, L.P.; Calado, C.R.C. Antibiotic Discovery: Where Have We Come from, Where Do We Go? Antibiotics 2019, 8, 45. [Google Scholar] [CrossRef] [PubMed]
- Antimicrobial Resistance: Main Topics (Animal Production). Available online: http://www.fao.org/antimicrobial-resistance/key-sectors/animal-production/en/ (accessed on 8 March 2021).
- Dossey, A.T.; Tatum, J.T.; McGill, W.L. Chapter 5—Modern Insect-Based Food Industry: Current Status, Insect Processing Technology, and Recommendations Moving forward. In Insects as Sustainable Food Ingredients; Dossey, A.T., Morales-Ramos, J.A., Rojas, M.G., Eds.; Academic Press: Cambridge, MA, USA, 2016; pp. 113–152. [Google Scholar]
- Cappellozza, S.; Leonardi, M.G.; Savoldelli, S.; Carminati, D.; Rizzolo, A.; Cortellino, G.; Terova, G.; Moretto, E.; Badaile, A.; Concheri, G.; et al. First Attempt to Produce Proteins from Insects by Means of a Circular Economy. Animals 2019, 9, 278. [Google Scholar] [CrossRef]
- Grekov, D.; Kipriotis, E.; Tzenov, P. Sericulture Training Manual; National Agricultural Research Foundation: Komotini, Greece, 2005; 320p. [Google Scholar]
- Naviglio, D.; Scarano, P.; Ciaravolo, M.; Gallo, M. Rapid Solid-Liquid Dynamic Extraction (RSLDE): A Powerful and Greener Alternative to the Latest Solid-Liquid Extraction Techniques. Foods 2019, 8, 245. [Google Scholar] [CrossRef]
- Naviglio, D. Naviglio’s Principle and Presentation of an Innovative Solid-Liquid Extraction Technology: Extractor Naviglio. Anal. Lett. 2003, 36, 1647–1659. [Google Scholar] [CrossRef]
- UNI EN ISO 665: 2020. Determination of Moisture and Volatile Matter Content; UNI—Ente Italiano di Normazione: Milano, Italy, 2020. [Google Scholar]
- UNI EN ISO 659: 2009. Oilseeds—Determination of Oil Content (Reference Method); UNI—Ente Italiano di Normazione: Milano, Italy, 2009. [Google Scholar]
- ISO 660: 2020. Determination of Acid Value and Acidity; ISO—International Organization for Standardization, 401-1214; Vernier: Geneva, Switzerland, 2020. [Google Scholar]
- ISO 3960: 2017. Determination of Peroxide Value—Iodometric (Visual) Endpoint Determination; ISO—International Organization for Standardization, 401-1214; Vernier: Geneva, Switzerland, 2017. [Google Scholar]
- ISO 12966. Animal and Vegetable Fats and Oils Gas Chromatography of Fatty Acid Methyl Esters Part 2: 2017 Preparation of Methyl Esters of Fatty Acids; ISO—International Organization for Standardization, 401-1214; Vernier: Geneva, Switzerland, 2017. [Google Scholar]
- Spranghers, T.; Ottoboni, M.; Klootwijk, C.; Ovyn, A.; Deboosere, S.; De Meulenaer, B.; Michiels, J.; Eeckhout, M.; De Clerq, P.; De Smet, S. Nutritional Composition of Black Soldier Fly (Hermetia illucens) Prepupae Reared on Different Organic Substrates. J. Sci. Food Agric. 2017, 97, 2594–2600. [Google Scholar] [CrossRef]
- Scala, A.; Cammack, J.A.; Salvia, R.; Scienzo, C.; Franco, A.; Bufo, S.A.; Tomberlin, J.K.; Falabella, P. Rearing Substrate Impacts Growth and Macronutrient Composition of Hermetia illucens (L.) (Diptera: Stratiomyidae) Larvae Produced at an Industrial scale. Sci. Rep. 2020, 10, 19448. [Google Scholar] [CrossRef] [PubMed]
- Cappellozza, L.; Cappellozza, S.; Saviane, A.; Sbrenna, G. Artificial Diet Rearing System for the Silkworm Bombyx mori (Lepidoptera: Bombycidae): Effect of Vitamin C Deprivation on Larval Growth and Cocoon Production. Appl. Entom. Zool. 2005, 40, 405–412. [Google Scholar] [CrossRef]
- Dong, H.L.; Zhang, S.X.; Tao, H.; Chen, Z.H.; Li, X.; Qiu, J.F.; Cui, W.Z.; Sima, Y.H.; Cui, W.Z.; Xu, S.Q. Metabolomics Differences between Silkworms (Bombyx mori) Reared on Fresh Mulberry (Morus) Leaves or Artificial Diets. Sci. Rep. 2017, 7, 10972. [Google Scholar] [CrossRef]
- Bhattacharyya, P.; Jha, S.; Mandal, P.; Ghosh, A. Artificial Diet Based Silkworm Rearing System: A Review. Int. J. Pure App. Biosci. 2016, 4, 114–122. [Google Scholar] [CrossRef]
- Ewald, N.; Vidakovic, A.; Langeland, M.; Kiessling, A.; Sampels, S.; Lalander, C. Fatty Acid Composition of Black Soldier Fly Larvae (Hermetia illucens) Possibilities and Limitations for Modification through Diet. Waste Manag. 2020, 102, 40–47. [Google Scholar] [CrossRef] [PubMed]
- Chieco, C.; Morrone, L.; Bertazza, G.; Cappellozza, S.; Saviane, A.; Gai, F.; Di Virgilio, N.; Rossi, F. The Effect of Strain and Rearing Medium on the Chemical Composition, Fatty Acid Profile and Carotenoid Content in Silkworm (Bombyx mori) Pupae. Animals 2019, 9, 103. [Google Scholar] [CrossRef] [PubMed]
- Altomare, A.A.; Baron, G.; Aldini, G.; Carini, M.; D’Amato, A. Silkworm Pupae as Source of High-Value Edible Proteins and of Bioactive Peptides. Food Sci. Nutr. 2020, 8, 2652–2661. [Google Scholar] [CrossRef]
- Zou, Y.; Hu, T.; Shi, Y.; Liao, S.; Liu, J.; Mu, L.; Chen, C.Y.O. Silkworm pupae oil exerts hypercholesterolemic and antioxidant effects in high-cholesterol diet-fed rats. J. Sci. Food Agric. 2017, 97, 2050–2056. [Google Scholar] [CrossRef] [PubMed]
- Hu, B.; Li, C.; Zhang, Z.; Zhao, Q.; Zhu, Y.; Su, Z.; Chen, Y. Microwave-Assisted Extraction of Silkworm Pupal Oil and Evaluation of its Fatty Acid Composition, Physicochemical Properties and Antioxidant Activities. Food Chem. 2017, 231, 348–355. [Google Scholar] [CrossRef]
- Chen, H.; Tian, J.; Wang, Y.; Yang, K.; Ji, H.; Li, J. Effects of Dietary Soybean Oil Replacement by Silkworm, Bombyx mori L., Chrysalis Oil on Growth Performance, Tissue Fatty Acid Composition, and Health Status of Juvenile Jian Carp Cyprinus Carpio var. Jian. J. World Aquacult. Soc. 2017, 48, 453–466. [Google Scholar] [CrossRef]
- Tomotake, H.; Katagiri, M.; Yamato, M. Silkworm Pupae (Bombyx mori) are New Sources of High Quality Protein and Lipid. J. Nutr. Sci. Vitaminol. 2010, 56, 446–448. [Google Scholar] [CrossRef]
- Meneguz, M.; Schiavone, A.; Gai, F.; Dama, A.; Lussiana, C.; Renna, M.; Gasco, L. Effect of Rearing Substrate on Growth Performance, Waste Reduction Efficiency and Chemical Composition of Black Soldier Fly (Hermetia illucens) Larvae. J. Sci. Food Agric. 2018, 98, 5776–5784. [Google Scholar] [CrossRef]
- Giannetto, A.; Oliva, S.; Ceccon Lanes, C.F.; de Araújo Pedron, F.; Savastano, D.; Baviera, C.; Parrino, V.; Lo Paro, G.; Spanò, N.C.; Cappello, T.; et al. (Diptera: Stratiomydae) Larvae and Prepupae: Biomass Production, Fatty Acid Profile and Expression of Key Genes Involved in Lipid Metabolism. J. Biotechnol. 2020, 307, 44–54. [Google Scholar] [CrossRef] [PubMed]
- Alifian, M.D.; Sholikin, M.M.; Evvyernie, D. Nahrowi. Potential Fatty Acid Composition of Hermetia illucens Oil Reared on Different Substrates. IOP Conf. Ser. 2019, 546, 062002. [Google Scholar] [CrossRef]
- Tzompa-Sosa, D.A.; Yi, L.; van Valenberg, H.J.F.; Lakemond, C.M.M. Four Insect Oils as Food Ingredient: Physical and Chemical Characterisation of Insect Oils Obtained by an Aqueous Oil Extraction. J. Insect Food Feed 2019, 5, 279–292. [Google Scholar] [CrossRef]
- Tzompa-Sosa, D.A.; Yi, L.; van Valenberg, H.J.F.; van Boekel, M.A.J.S.; Lakemond, C.M.M. Insect Lipid Profile: Aqueous versus Organic Solvent-Based Extraction Methods. Food Res. Int. 2014, 62, 1087–1094. [Google Scholar] [CrossRef]
- Pimentel, A.C.; Montali, A.; Bruno, D.; Tettamanti, G. Metabolic Adjustment of the Larval Fat Body in Hermetia illucens to Dietary Conditions. J. Asia Pac. Entomol. 2017, 20, 1307–1313. [Google Scholar] [CrossRef]
- Arrese, E.L.; Soulages, J.L. Insect Fat Body: Energy, Metabolism, and Regulation. Annu. Rev. Entomol. 2010, 55, 207–225. [Google Scholar] [CrossRef]
- Sakaguchi, B. Postembryonic Development of the Silkworm. In The Silkworm: An Important Laboratory Tool; Tazima, Y., Ed.; Kodansha: Tokyo, Japan, 1978; pp. 31–51. [Google Scholar]
- Azzollini, D.; van Iwaarden, A.; Lakemond, C.M.M.; Fogliano, V. Mechanical and Enzyme Assisted Fractionation Process for a Sustainable Production of Black Soldier Fly (Hermetia illucens) Ingredients. Front. Sustain. Food Syst. 2020, 4, 80. [Google Scholar] [CrossRef]
- Surendraa, K.C.; Olivierb, R.; Tomberlinc, J.K.; Jhad, R.; Khanala, S.K. Bioconversion of Organic Wastes into Biodiesel and Animal Feed via Insect Farming. Renew. Energy 2016, 98, 197–202. [Google Scholar] [CrossRef]
- Tonga, C.M.; Broeck, J.V.; Kynyuri, J. Influence of Processing Methods on Techno-Functional Properties of Flours from Three Edible Insects. In Proceedings of the Conference On-Line Insects as Food and Feed, Quebéc City, QB, Canada, 23–26 November 2020; Available online: http://ifw2020.org/ (accessed on 30 January 2020).
- 14.10.1: Foods-Acid Value and the Quality of Fats and Oils. Available online: https://batch.libretexts.org/print/url=https://chem.libretexts.org/Bookshelves/General_Chemistry/Book%3A_ChemPRIME_(Moore_et_al.)/14%3A_Ionic_Equilibria_in_Aqueous_Solutions/14.10%3A_Titration_Curves/14.10.01%3A_Foods-_Acid_Value_and_the_Quality_of_Fats_and_Oils.pdf (accessed on 30 January 2020).
- Montevecchi, G.; Zanasi, L.; Masino, F.; Maistrello, L.; Antonelli, A. Black Soldier Fly (Hermetia illucens L.): Effect on the Fat Integrity Using Different Approaches to the Killing of the Prepupae. J. Insects Food Feed 2019, 6, 121–131. [Google Scholar] [CrossRef]
- McGaw, L.J.; Jäger, A.K.; van Staden, A.K. Antibacterial Effects of Fatty Acids and Related Compounds from Plants. S. Afr. J. Bot. 2002, 68, 4. [Google Scholar] [CrossRef]
- Marusich, E.; Mohamed, H.; Afanasev, Y.; Leonov, S. Fatty Acids from Hermetia illucens Larvae Fat Inhibit the Proliferation and Growth of Actual Phytopathogens. Microorganisms 2020, 8, 1423. [Google Scholar] [CrossRef] [PubMed]
- Zheng, C.J.; Yoo, J.-S.; Lee, T.-G.; Cho, H.-Y.; Kim, Y.-H.; Kim, W.-G. Fatty Acid Synthesis is a Target for Antibacterial Activity of Unsaturated Fatty Acids. FEBS Lett. 2005. [Google Scholar] [CrossRef]
- Bergsson, G.; Arnfinnsson, J.; Steingrímsson, O.; Thormar, H. Killing of Gram-Positive Cocci by Fatty Acids and MonoglycerIdes. APMIS 2001, 109, 670–678. [Google Scholar] [CrossRef]
- Fischer, C.L.; Drake, D.R.; Dawson, D.V.; Blanchette, D.R.; Brogden, K.A.; Wertz, P.W. Antibacterial Activity of Sphingoid Bases and Fatty Acids against Gram-Positive and Gram-Negative Bacteria. Antimicrob. Agents Chemother. 2012, 56, 1157–1161. [Google Scholar] [CrossRef]
- Desbois, A.P.; Smith, V.J. Antibacterial Free Fatty Acids: Activities, Mechanisms of Action and Biotechnological Potential. Appl. Microbiol. Biotechnol. 2009, 85, 1629–1642. [Google Scholar] [CrossRef] [PubMed]
- Desbois, A.P. Potential Applications of Antimicrobial Fatty Acids in Medicine, Agriculture and Other Industries. Recent Pat. Antiinfect. Drug Discov. 2012, 7, 111–122. [Google Scholar] [CrossRef]
- Desbois, A.P.; Lawlor, K.C. Antibacterial Activity of Long-Chain Polyunsaturated Fatty Acids against Propionibacterium acnes Staphylococcus aureus. Mar. Drugs 2013, 11, 4544–4557. [Google Scholar] [CrossRef]
- Vogel, H.; Müller, A.; Heckel, D.G.; Gutzeit, H.; Vilcinskas, A. Nutritional Immunology: Diversification and Diet-Dependent Expression of Antimicrobial Peptides in the Black Soldier Fly Hermetia illucens. Dev. Comp. Immunol. 2018, 78, 141–148. [Google Scholar] [CrossRef] [PubMed]
- Nesaa, J.; Sadatb, A.; Buccinic, D.F.; Kati, A.; Mandal, A.K.; Franco, O.L. Antimicrobial Peptides from Bombyx mori: A Splendid Immune Defense Response in Silkworms. RSC Adv. 2020, 10, 512–523. [Google Scholar] [CrossRef]
- Moretta, A.; Salvia, R.; Scieuzo, C.; Vogel, H.; Pucci, P.; Sgambato, A.; Wolff, M.; Falabella, P. A Bioinformatic Study of Antimicrobial Peptides Identified in the Black Soldier Fly (BSF) Hermetia illucens (Diptera: Stratiomyidae). Sci. Rep. 2020, 10, 16875. [Google Scholar] [CrossRef] [PubMed]
- Romoli, O.; Saviane, A.; Bozzato, A.; D’Antona, P.; Tettamanti, G.; Squartini, A.; Cappellozza, S.; Sandrelli, F. Differential Sensitivity to Infections and Antimicrobial Peptide-Mediated Immune Response in Four Silkworm Strains with Different Geographical Origin. Sci Rep. 2017, 7, 1048. [Google Scholar] [CrossRef] [PubMed]

| Larval Samples | Dry Matter (DM) (%) | Rehydrated Weight (g) * | Lipids (g/100g DM) |
|---|---|---|---|
| Dried at 70 °C until constant weight | 98.03 | - | 30.61 |
| After water extraction at 70 °C | 42.71 | 112 | 26.59 |
| After water extraction at 100 °C | 25.14 | 183 | 24.10 |
| Naviglio Test Number | Weight of Sample before Extraction (g of DM) | Weight of Sample after Extraction (g of DM) | Extracted Lipids (g) | Extracted Lipids (% of Initial DM) |
|---|---|---|---|---|
| 1 | 50 | 39 | 0.36 | 0.72 |
| 2 | 50 | 40 | 0.27 | 0.54 |
| 3 | 50 | 40 | 2.65 | 5.31 |
| 4 | 50 | 40 | 0.14 | 0.28 |
| Fatty Acids | Notation | A | B | C | D |
|---|---|---|---|---|---|
| M ± Ue | M ± Ue | M ± Ue | M ± Ue | ||
| Lauric acid | C12:0 | 0.06 ± 0.01 | 0.05 ± 0.01 | 0.06 ± 0.01 | 0.04 ± 0.01 |
| Myristic acid | C14:0 | 0.18 ± 0.01 | 0.15 ± 0.01 | 0.14 ± 0.01 | 0.16 ± 0.01 |
| Myristoleic acid | C14:1 | 0.03 ± 0.01 | 0.02 ± 0.01 | 0.03 ± 0.01 | 0.00 ± 0.00 |
| Pentadecyclic acid | C15:0 | 0.07 ± 0.02 | 0.03 ± 0.01 | 0.03 ± 0.01 | 0.04 ± 0.01 |
| Pentadecanoic acid | C15:1 | 0.07 ± 0.02 | 0.08 ± 0.02 | 0.07 ± 0.02 | 0.08 ± 0.02 |
| Palmitic acid | C16:0 | 24.45 ± 2.38 | 23.34 ± 2.38 | 21.76 ± 2.38 | 22.07 ± 2.38 |
| Palmitoleic acid | C16:1 | 1.56 ± 0.32 | 1.39 ± 0.32 | 1.14 ± 0.32 | 1.14 ± 0.32 |
| Margaric acid | C17:0 | 0.16 ± 0.01 | 0.14 ± 0.01 | 0.17 ± 0.01 | 0.13 ± 0.01 |
| Heptadecenoic acid | C17:1 | 0.04 ± 0.02 | 0.03 ± 0.02 | 0.03 ± 0.02 | 0.03 ± 0.02 |
| Stearic acid | C18:0 | 4.35 ± 0.15 | 4.47 ± 0.15 | 5.01 ± 0.15 | 4.21 ± 0.15 |
| Oleic acid | C18:1 | 31.17 ± 2.44 | 31.75 ± 2.44 | 32.40 ± 2.44 | 25.80 ± 2.44 |
| Linoleic acid | C18:2(n-6) | 4.64 ± 0.29 | 5.11 ± 0.29 | 6.29 ± 0.29 | 7.50 ± 0.29 |
| Arachidic acid | C20:0 | 0.16 ± 0.02 | 0.17 ± 0.02 | 0.19 ± 0.02 | 0.19 ± 0.02 |
| Eicosenoic acid | C20:1 | 0.02 ± 0.01 | 0.02 ± 0.01 | 0.04 ± 0.01 | 0.04 ± 0.01 |
| Linolenic acid | C18:3(n-3) | 32.68 ± 0.26 | 32.88 ± 0.26 | 32.25 ± 0.26 | 38.18 ± 0.26 |
| Behenic acid | C22:0 | 0.01 ± 0.02 | 0.01 ± 0.02 | 0.01 ± 0.02 | 0.01 ± 0.02 |
| Erucic acid | C22:1 | 0.08 ± 0.01 | 0.08 ± 0.08 | 0.11 ± 0.02 | 0.12 ± 0.02 |
| Lignoceric acid | C24:0 | 0.03 ± 0.08 | 0.02 ± 0.01 | 0.05 ± 0.08 | 0.02 ± 0.08 |
| Oleic acid, trans isomer | C18:1t | 0.04 ± 0.06 | 0.03 ± 0.06 | 0.04 ± 0.06 | 0.03 ± 0.06 |
| Linoleic acids, trans isomer | C18:2t | 0.03 ± 0.06 | 0.07 ± 0.01 | <0.01 | <0.01 |
| Linolenic acids, trans isomer | C18:3t | 0.25 ± 0.10 | 0.22 ± 0.24 | 0.20 ± 0.10 | 0.24 ± 0.10 |
| SFA/UFA ratio | 0.42 | 0.40 | 0.38 | 0.37 | |
| ω6/ω3 ratio | 0.14 | 0.16 | 0.19 | 0.20 | |
| Parameters | Unit | A | B | C | D |
|---|---|---|---|---|---|
| Moisture and volatile matter | % m/m | 5.89 ± 0.51 | 9.78 ± 0.26 | 7.73 ± 0.22 | 7.84 ± 0.31 |
| Oil content | % m/m | 30.01± 0.75 | 28.64 ± 0.75 | 24.37 ± 0.75 | 25.78 ± 0.75 |
| Acidity | % oleic acid | 2.4 ± 0.1 | 3.2 ±0.1 | 26.0 ± 1.2 | 2.8 ± 0.1 |
| PV | mEq O2/kg | 2.7 ± 0.4 | 6.1 ± 0.9 | 2.9 ± 0.4 | 13.3 ± 2.1 |
| Treatments | H. illucens | B. mori | ||
|---|---|---|---|---|
| B. subtilis | S. aureus | B. subtilis | S. aureus | |
| Oil/DMSO (1:1) | 18.60 ± 1.04 A, B | 12.60 ± 1.80 | 13.75 ± 1.89 | 13.30 ± 1.12A |
| OIL/DMF (1:1) | 12.67 ± 0.12 | 9.60 ± 2.75 | 10.83 ± 2.39 | 7.30 ± 2.00 |
Publisher’s Note: MDPI stays neutral with regard to jurisdictional claims in published maps and institutional affiliations. |
© 2021 by the authors. Licensee MDPI, Basel, Switzerland. This article is an open access article distributed under the terms and conditions of the Creative Commons Attribution (CC BY) license (http://creativecommons.org/licenses/by/4.0/).
Share and Cite
Saviane, A.; Tassoni, L.; Naviglio, D.; Lupi, D.; Savoldelli, S.; Bianchi, G.; Cortellino, G.; Bondioli, P.; Folegatti, L.; Casartelli, M.; et al. Mechanical Processing of Hermetia illucens Larvae and Bombyx mori Pupae Produces Oils with Antimicrobial Activity. Animals 2021, 11, 783. https://doi.org/10.3390/ani11030783
Saviane A, Tassoni L, Naviglio D, Lupi D, Savoldelli S, Bianchi G, Cortellino G, Bondioli P, Folegatti L, Casartelli M, et al. Mechanical Processing of Hermetia illucens Larvae and Bombyx mori Pupae Produces Oils with Antimicrobial Activity. Animals. 2021; 11(3):783. https://doi.org/10.3390/ani11030783
Chicago/Turabian StyleSaviane, Alessio, Luca Tassoni, Daniele Naviglio, Daniela Lupi, Sara Savoldelli, Giulia Bianchi, Giovanna Cortellino, Paolo Bondioli, Liliana Folegatti, Morena Casartelli, and et al. 2021. "Mechanical Processing of Hermetia illucens Larvae and Bombyx mori Pupae Produces Oils with Antimicrobial Activity" Animals 11, no. 3: 783. https://doi.org/10.3390/ani11030783
APA StyleSaviane, A., Tassoni, L., Naviglio, D., Lupi, D., Savoldelli, S., Bianchi, G., Cortellino, G., Bondioli, P., Folegatti, L., Casartelli, M., Orlandi, V. T., Tettamanti, G., & Cappellozza, S. (2021). Mechanical Processing of Hermetia illucens Larvae and Bombyx mori Pupae Produces Oils with Antimicrobial Activity. Animals, 11(3), 783. https://doi.org/10.3390/ani11030783

